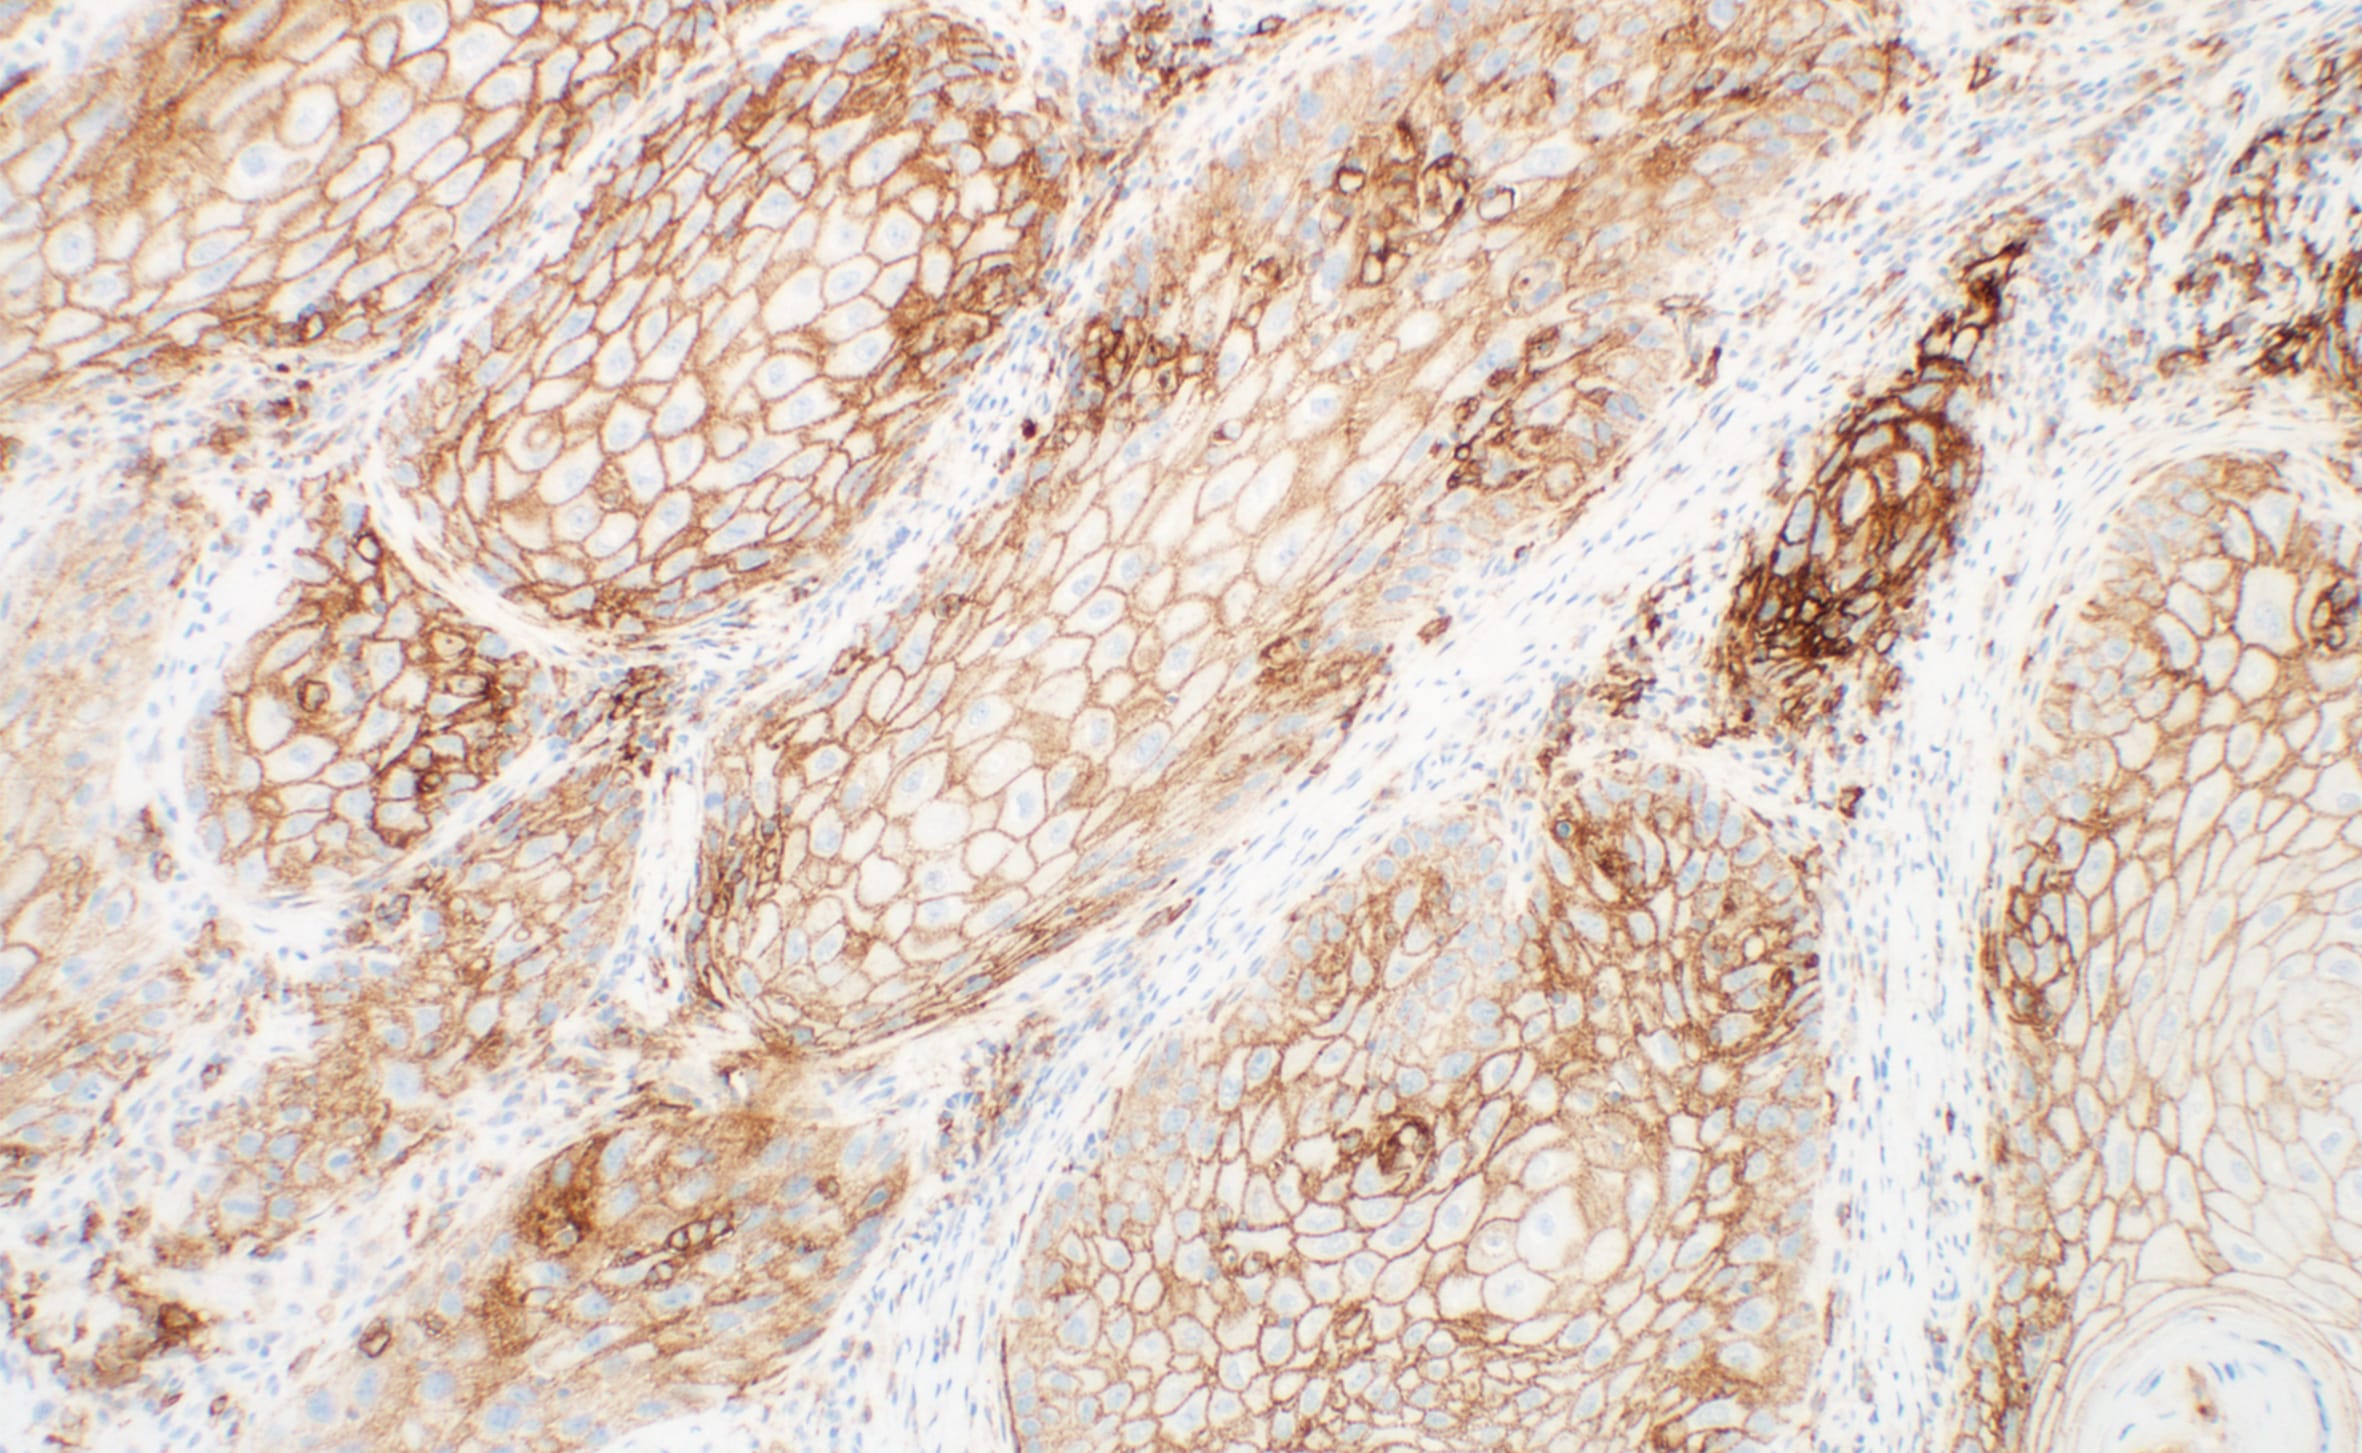

PD-L1 IHC 28-8 pharmDx「ダコ」の染色結果判定オンライントレーニングでは、本品による染色の詳細とスコアリング演習を通して、以下の知識を包括的に習得することができます。
- 免疫チェックポイントパスウェイの役割の理解
- 最適な染色結果を得るための技術的な注意事項の習得
- 本品で染色した非扁平上皮非小細胞肺癌、頭頸部癌、または悪性黒色腫組織検体の評価方法の習得
バーチャル顕微鏡を用いた染色結果のスコアリング演習による PD-L1 染色結果判定能力の向上のためにご利用ください。


染色結果判定トレーニング
染色結果判定トレーニング

使用目的について
体外診断用
PD-L1 IHC 28-8 pharmDx「ダコ」は、抗 PD-L1 ウサギモノクローナル抗体 (Clone 28-8) を用いた免疫組織化学法を原理としたアッセイキットです。ダコ Autostainer Link 48 (IHC 自動染色装置) を使用し、ホルマリン固定パラフィン包埋 (FFPE) 非扁平上皮非小細胞肺癌 (NSCLC)、頭頸部癌及び悪性黒色腫組織中の PD-L1 発現率の測定に使用することを目的としています。PD-L1 発現率は、強度を問わず完全または部分的な細胞膜染色を示す腫瘍細胞の割合により判断します。腫瘍細胞の PD-L1 の発現は、そのがんに特異的な染色結果を判定することにより判断します。
がん組織、細胞中の PD-L1 発現率の測定
非扁平上皮非小細胞肺癌患者及び頭頸部癌患者におけるニボルマブ (遺伝子組み換え) の適切な投与を行うための補助に用いる。
悪性黒色腫患者におけるニボルマブとイピリムマブの併用療法の適切な投与を行うための補助に用いる。1
参考文献
1. PD-L1 IHC 28-8 pharmDx「ダコ」添付文書